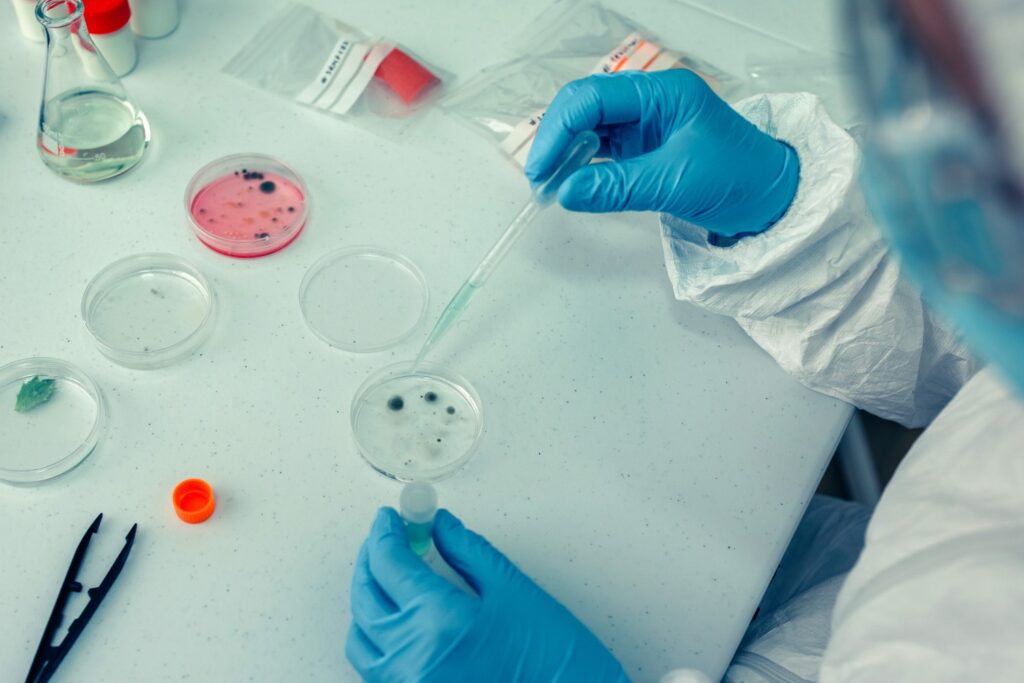
IVF Second Attempt

Something clicked one afternoon at Family Fertility & IVF Center Lahore. A scan showed a cyst in an ovary of...
Why Do Couples Still Avoid IVF When Struggle to Get Pregnant?
Struggling to conceive is a story many know all too well, but here’s the twist: when it comes to IVF,...
Checkups and Tests in 3rd Trimester: After 28 Weeks
The final stretch of pregnancy always arrives quicker than expected, catching many off guard. By 28 weeks, the belly feels...
Third Trimester Thrills and Challenges: How to Handle It
Third trimester. Weeks 28 to 40. The finish line looks close. The body disagrees. Muscles pull. Ribs complain. Sleep negotiates...
PCOS and Diet: Help You Manage Weight and Conceive Naturally
PCOS doesn’t just mess with hormones, it messes with life. The weight that won’t budge no matter how many diets...
IVF Second Attempt: Cost & Process in Pakistan
So, the first IVF attempt didn’t work. Disappointing? Absolutely. Expensive? Without a doubt. Emotionally draining? That doesn’t even begin to...
Triggering Life: Y-Sperm, Egg Maturity, and Gender Selection IUI
Gender preference. It’s not some hush-hush taboo anymore. People ask straight up. Want a son? Try IUI. This method is...
Current Research on Stem Cells for Fertility in Men and Women
Fertility struggles are more common than most people say out loud. Periods that don’t follow a schedule, low ovarian reserves,...
Fibroids in Women: Causes, Symptoms, and Treatment Options
Let’s talk about fibroids. No one really wants to, but it’s a reality. Six out of ten women are dealing...
PGTA Testing in Pakistan: Costs, Process, and What to Expect
A couple walks in after two tough IVF cycles. Call them Ayesha and Bilal. Good quality embryos. Great stimulation response....